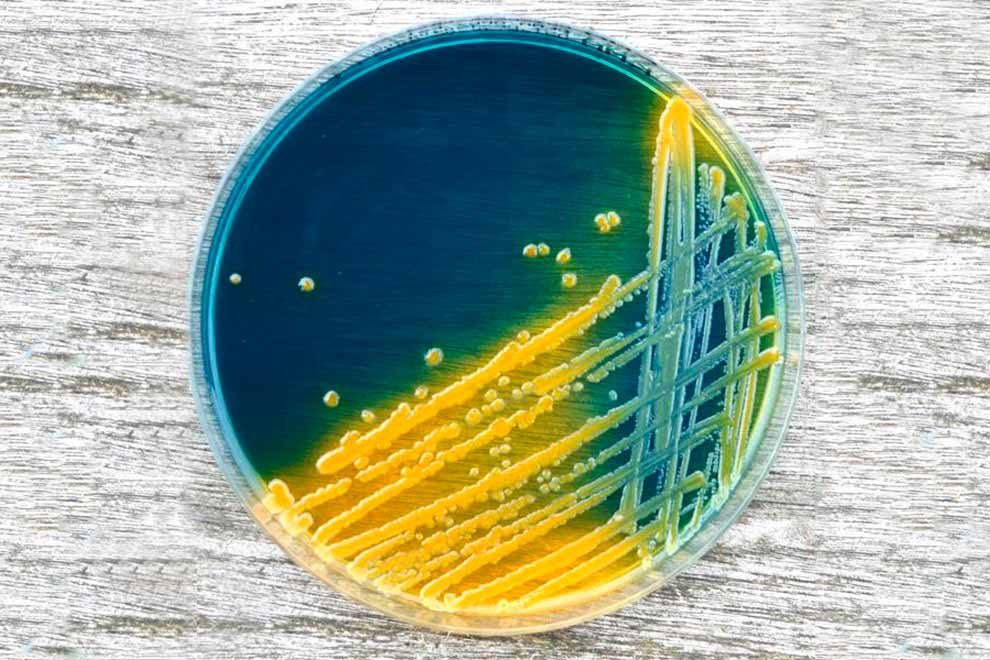

Investigadores de la Universidad Carlos III de Madrid (UC3M), la Universidad de Valladolid y la Universidad de León han estudiado cómo se adaptan cepas no patógenas de la bacteria Escherichia coli a diferentes condiciones para combatir a sus “hermanas” nocivas. Estos resultados pueden ayudar a mejorar la seguridad de los alimentos.
La E. coli es un habitante habitual del nuestro intestino. La mayoría de las cepas son inofensivas, pero pueden existir variantes patógenas que producen problemas gastrointestinales. Esta investigación ha estudiado cómo se adaptan las cepas no patógenas a diferentes condiciones para anticiparse al comportamiento de otras más nocivas.
Presencia en alimentos
El problema principal de esta bacteria es su presencia en algunos alimentos. Las versiones patógenas de E. coli tienen como reservorio al ganado vacuno. De ahí puede llegar a la cadena alimentaria, en el caso de que existan condiciones deficientes de limpieza y desinfección de locales, utensilios y/o una manipulación poco higiénica de los alimentos. Carnes mal cocinadas, productos lácteos no pasteurizados, verduras contaminadas y mal lavadas o agua contaminada podrían contener la toxina producida por esta bacteria, la mayor causante de gastroenteritis a nivel mundial.
El equipo investigador ha estudiado a través de unos modelos matemáticos la variabilidad entre las cepas patógenas y no patógenas de la bacteria para describir su comportamiento. Para ello, se cultivaron diferentes cepas patógenas y no patógenas de E. coli en tres medios diferentes: en el laboratorio, en leche y en jugo de carne. Después, se calcularon varios parámetros de crecimiento de los microorganismos, como el tiempo de latencia (el tiempo que necesita la bacteria para adaptarse al medio) y la velocidad máxima de crecimiento. Las condiciones de los experimentos en los tres medios intentaron recrear situaciones a temperatura ambiente superior a las de refrigeración (15, 20 o 25ºC) o a temperatura óptima para el microorganismo (30, 35 o 40ºC).
Estudio
El estudio ha demostrado que existe muy poca variabilidad entre las cepas patógenas y las otras no patógenas, ya que ambas tienen un comportamiento similar bajo las condiciones estudiadas. “Sus valores en cuanto a sus tiempos de latencia y sus velocidades máximas de crecimiento son equiparables, por lo tanto, se pueden emplear los datos de unas para predecir el comportamiento de otras”, afirma el investigador principal, Emiliano Quinto, del Área de Nutrición y Bromatología de la Universidad de Valladolid.
Para ello, se emplearon dos estrategias de estimación estadística desarrolladas en conjunto con un investigador de la UC3M. “Se trata de modelos probabilísticos avanzados donde se ha utilizado una distribución general que engloba una amplia familia de distribuciones estándar”, explica Juan Miguel Marín, investigador del Dpto. de Estadística de la UC3M. La primera de ellas es paramétrica, basada en una distribución general sobre medidas positivas, y el segundo de tipo no paramétrico, mediante métodos de remuestreo bootstrap.
Transferencia del conocimiento
El objetivo principal de esta investigación, publicada recientemente en la revista científica Food Research International, es anticiparse al comportamiento de bacterias más peligrosas. Para ello, es interesante conocer el tiempo que van a necesitar para adecuarse a un medio y estimar su velocidad de reproducción. Este conocimiento tiene una aplicación práctica en el análisis de riesgos en la industria alimentaria.
Con los datos obtenidos de las cepas no patógenas de E. coli, se puede conocer el comportamiento de las patógenas y atajar su multiplicación a lo largo de la cadena alimenticia. Es decir, se sabe cuándo hay que emplear los medios técnicos disponibles en la industria alimenticia (refrigeración, esterilización o pasteurización) para acabar con la reproducción de la bacteria y no permitir que se genere la toxina asociada a problemas intestinales.
“En la industria alimentaria, nos interesa saber en qué momento se tienen que emplear ciertos tratamientos técnicos. Lo ideal es abordar la bacteria antes de que acabe su tiempo de adaptación para que no tenga tiempo de reproducirse”, añade Emiliano Quinto.